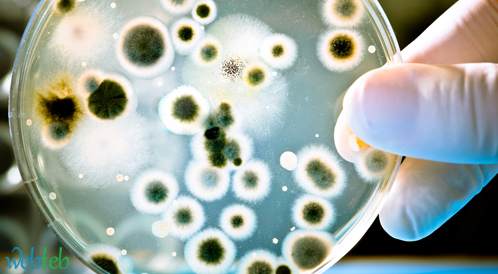

عدوى بكتيرية تثير الخوف في بريطانيا.. الأطفال الأكثر تضررا
أعلنت المملكة المتحدة، الجمعة، تسجيل 5 وفيات خلال 7 أيام بسبب عدوى بكتيريا المكورات العنقودية "أي"، لدى أطفال دون سن الـ10، الأمر الذي أثار مخاوف صحية من احتمال تحور هذا النوع من الأمراض.
ووفق وكالة الأمن الصحي في المملكة المتحدة، فإن هذا النوع من العدوى البكتيرية قادر على التسبب بالعديد من الأمراض، بعضها بسيط وأخرى فتاكة.
ذكرت الوكالة أن معدل الإصابة بهذه العدوى في إنجلترا هذه السنة لدى كل 100 ألف طفل تتراوح أعمارهم بين سنة واحدة و4 أعوام، كان في حدود 2.3 حالة، بينما كان هذا الرقم في حدود 0.5 خلال الفترة ما بين 2017 و2019.
بالنسبة للأطفال الذين تتراوح أعمارهم بين 5 و9 سنوات، سجلت 1.1 حالة لكل 100 ألف طفل، مقارنة بـ0.3 بين عامي 2017 و2019.
تعليقا على هذه الأرقام، قالت هيئة خدمات الصحة والخدمات الإنسانية في المملكة المتحدة، إن التحقيقات جارية بعد ورود تقارير عن زيادة عدوى بكتيريا المكورات العنقودية "أي" في الجهاز التنفسي السفلي لدى الأطفال خلال الأسابيع القليلة الماضية.
أضافت الهيئة أنه لا يوجد دليل يشير إلى انتشار سلالة جديدة من هذه البكتيريا، حسبما نقلت شبكة "سكاي نيوز" البريطانية.
أوضحت الهيئة أن البيانات الأخيرة تظهر أن حالات الحمى القرمزية التي تسببها البكتيريا لا تزال أعلى مما نراه عادة في هذا الوقت من العام، إذ تم الإبلاغ عن 851 حالة الأسبوع الماضي، مقارنة بـ186 حالة في السنوات السابقة.
الأعراض وكيفية الانتشار
- بحسب المستشار في هيئة خدمات الصحة والخدمات الإنسانية بالمملكة المتحدة ييمي تشاو، فإن أعراض الإصابة ببكتيريا المكورات العنقودية "أي"، يمكن أن تكون التهابا في الحلق وحمى والتهابات الجلد الطفيفة، ويمكن علاجها بدورة كاملة من المضادات الحيوية.
- بيّن تشاو أنه "في حالات نادرة، يمكن أن تتسبب البكتيريا بأعراض قوية وخطيرة مثل ارتفاع في درجة الحرارة وآلام شديدة في العضلات وقيء أو إسهال، وعندها يجب طلب المساعدة العاجلة".
- عن طرق انتشار البكتيريا، قال تشاو إن ذلك يتم من خلال السعال والعطس وملامسة الجلد للجلد.
- حذر تشاو من أن الأشخاص الذين تزيد أعمارهم عن 65 عاما، أو أولئك المصابين بفيروس نقص المناعة "الإيدز"، أو الذين يستخدمون المنشطات، أو الذين يعانون من مرض السكري أو أمراض القلب أو السرطان هم الأكثر عرضة للإصابة بالعدوى.
المصدر: سكاي نيوز